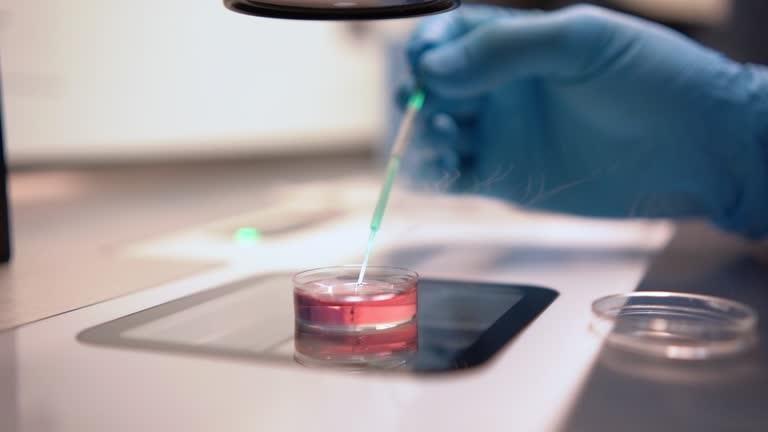
Semen Analysis

Our Services
We offer a comprehensive range of fertility treatments and diagnostic services.
Preconception
Preconception counselling helps individuals and couples prepare for a healthy pregnancy by assessing medical history, lifestyle, age-related fertility, and potential genetic risks. At HomeIVF, we offer expert guidance to optimise fertility and manage health conditions like thyroid issues, endometriosis, or cancer history. Whether you’re planning naturally or considering fertility treatment at home, preconception counselling empowers you to make informed, confident decisions for your parenthood journey.

Preconception Specialists

Our Doctors
Have Questions? Learn More

Semen Analysis→
Understand what parameters are measured in a semen analysis and what the results mean for fertility.

Laparoscopy→
Minimally invasive surgical procedure used to examine and treat conditions affecting fertility.
Amniocentesis→
Learn about this prenatal diagnostic test that analyzes amniotic fluid for genetic conditions.
Explore Other Services
Other Services
Genetic Compatibility
Assesses genetics of parents to identify potential hereditary risks for offspring.
Egg Freezing
Preserves a woman's eggs for future use, allowing flexibility in family planning.
Conception Support
Provides comprehensive care for reproductive health and fertility concerns.









